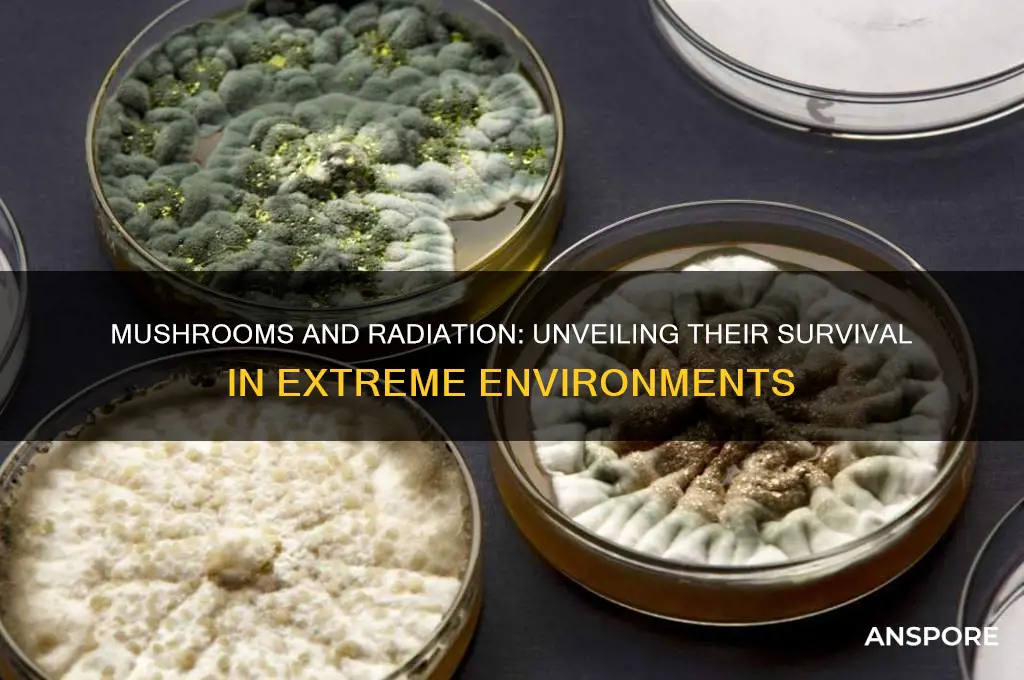
can mushrooms grow in radiation

Mushrooms, known for their resilience and adaptability, have sparked curiosity regarding their ability to grow in radioactive environments. While radiation is generally harmful to most living organisms, certain mushroom species, such as those in the genus *Cladosporium* and *Cryptococcus*, have been observed thriving in areas with elevated radiation levels, including the Chernobyl Exclusion Zone. These fungi exhibit unique properties, such as melanin production, which may act as a protective mechanism against radiation damage. Research suggests that some mushrooms not only survive but also contribute to the breakdown of radioactive materials through a process called bioremediation. This phenomenon raises intriguing questions about the potential role of fungi in mitigating radiation contamination and their broader ecological significance in extreme environments.
| Characteristics | Values |
|---|---|
| Can Mushrooms Grow in Radiation? | Yes, certain mushroom species can grow in radiation-rich environments, including areas contaminated by nuclear accidents like Chernobyl and Fukushima. |
| Radiation Tolerance | Some mushrooms, such as Cladosporium sphaerospermum and Cryptococcus neoformans, exhibit high tolerance to ionizing radiation due to their melanin content, which acts as a radioprotective agent. |
| Mechanism of Tolerance | Melanin in mushrooms scavenges free radicals generated by radiation, reducing cellular damage. Additionally, some fungi repair DNA more efficiently in response to radiation exposure. |
| Examples of Radiation-Resistant Mushrooms | Cladosporium sphaerospermum, Cryptococcus neoformans, Wangiella dermatitidis, and certain species of Aspergillus and Penicillium. |
| Applications | Radiation-resistant mushrooms are studied for bioremediation (cleaning up radioactive waste), radiation protection in space exploration, and understanding extremophile biology. |
| Growth in Radioactive Environments | Mushrooms have been observed growing in the Chernobyl Exclusion Zone and Fukushima, where they thrive despite high radiation levels, often outcompeting other organisms. |
| Potential Risks | Consuming mushrooms from radioactive areas can pose health risks due to bioaccumulation of radioactive isotopes like cesium-137. |
| Research Status | Ongoing research focuses on understanding the genetic and biochemical mechanisms behind fungal radiation resistance and their potential applications. |
Explore related products
What You'll Learn

Radiation-resistant mushroom species
Certain mushroom species exhibit remarkable resilience to radiation, thriving in environments that would be inhospitable to most life forms. One notable example is the *Cryptococcus neoformans*, a fungus known to inhabit areas with high natural background radiation, such as the Chernobyl Exclusion Zone. Studies have shown that this species can withstand radiation doses up to 1,000 Gray (Gy), far exceeding the lethal limit for humans, which is approximately 5 Gy. This extraordinary tolerance is attributed to the fungus’s robust DNA repair mechanisms and melanin-rich cell walls, which act as a protective shield against ionizing radiation.
To cultivate radiation-resistant mushrooms, such as *C. neoformans* or *Cladosporium sphaerospermum*, specific conditions must be replicated. These fungi thrive in nutrient-poor, high-radiation environments, often found in nuclear accident sites or naturally radioactive soils. For home or laboratory cultivation, simulate these conditions by using agar plates enriched with minimal nutrients and exposing them to controlled low-dose radiation sources, such as X-ray machines or gamma irradiators. Caution: Always adhere to safety protocols when handling radioactive materials, including wearing protective gear and ensuring proper ventilation.
Comparatively, radiation-resistant mushrooms like *C. sphaerospermum* have been studied for their potential in bioremediation, particularly in decontaminating radioactive waste. Their ability to absorb and accumulate radioactive isotopes, such as cesium-137 and strontium-90, makes them valuable in cleaning up nuclear sites. For instance, a 2011 study demonstrated that this fungus could reduce radioactive cesium levels in contaminated soil by up to 90% within weeks. This application highlights the practical benefits of understanding and harnessing these species’ unique capabilities.
Descriptively, radiation-resistant mushrooms often display distinct morphological adaptations. Their thick, melanized cell walls not only protect against radiation but also contribute to their dark pigmentation, a trait commonly observed in species like *Wangiella dermatitidis*. These fungi’s ability to form biofilms further enhances their survival in harsh conditions, allowing them to colonize surfaces and resist environmental stressors. Observing these adaptations provides insight into the evolutionary strategies employed by organisms in extreme habitats.
In conclusion, radiation-resistant mushroom species offer both scientific intrigue and practical applications. From their role in bioremediation to their potential in understanding DNA repair mechanisms, these fungi exemplify nature’s ingenuity in adapting to extreme environments. Whether cultivated for research or applied in real-world solutions, their study opens new avenues for addressing challenges posed by radiation contamination.
Can Mushrooms Infect Human Flesh? Unraveling the Myth and Reality
You may want to see also

Effects of radiation on mushroom growth
Mushrooms, often associated with damp, dark environments, exhibit surprising resilience in the face of radiation. Studies have shown that certain mushroom species not only survive but thrive in radioactive conditions. For instance, the black fungus *Cryptococcus neoformans* has been observed growing inside the Chernobyl Nuclear Power Plant, where radiation levels remain high decades after the disaster. This phenomenon raises questions about the mechanisms mushrooms employ to withstand radiation and whether these traits can be harnessed for environmental or medical purposes.
Analyzing the effects of radiation on mushroom growth reveals a complex interplay between dosage and species adaptability. Low to moderate radiation levels (up to 100 Gy) can stimulate growth in some mushrooms by inducing DNA repair mechanisms and enhancing metabolic activity. However, higher doses (above 500 Gy) typically inhibit growth, causing cellular damage and reducing spore viability. For example, *Reishi* (*Ganoderma lucidum*) shows increased biomass production at 50 Gy but suffers significant growth retardation at 1,000 Gy. Understanding these thresholds is crucial for applications like bioremediation, where mushrooms could be used to clean up radioactive sites.
To cultivate mushrooms in radiation-contaminated areas, specific steps must be followed. First, select radiation-tolerant species like *Cladosporium sphaerospermum* or *Wangiella dermatitidis*. Second, monitor radiation levels using a Geiger counter to ensure they fall within the species’ tolerance range. Third, provide a nutrient-rich substrate, such as wood chips or straw, to support growth despite environmental stress. Caution: avoid consuming mushrooms grown in highly radioactive areas, as they may accumulate harmful isotopes. Instead, focus on their potential for decontaminating soil rather than food production.
Comparing mushrooms to other organisms highlights their unique ability to cope with radiation. Unlike plants, which often suffer immediate damage to their photosynthetic systems, mushrooms lack chlorophyll and rely on decomposing organic matter, making them less susceptible to radiation-induced metabolic disruption. Additionally, their chitinous cell walls provide structural protection against radiation damage. This comparative advantage positions mushrooms as ideal candidates for studying radiation resistance and developing bioinspired technologies, such as radiation-shielding materials or radiation-tolerant crops.
In conclusion, the effects of radiation on mushroom growth are dose-dependent and species-specific, with some mushrooms exhibiting remarkable adaptability. By understanding these dynamics, we can leverage mushrooms for bioremediation, scientific research, and potentially even space exploration, where radiation exposure is a significant challenge. Practical applications require careful species selection, radiation monitoring, and ethical considerations to ensure safety and efficacy.
Can Mushrooms Thrive in Caves? Exploring Underground Fungal Growth
You may want to see also

Mushrooms in Chernobyl ecosystem
The Chernobyl Exclusion Zone, a 2600-square-kilometer area evacuated after the 1986 nuclear disaster, has become an unintended laboratory for studying life in radioactive environments. Among the organisms thriving here, mushrooms stand out for their resilience and adaptability. Unlike animals, which often exhibit genetic mutations or reduced lifespans in high-radiation areas, certain mushroom species not only survive but flourish, absorbing and accumulating radioactive isotopes like cesium-137 and strontium-90. This unique ability has made them both a subject of scientific fascination and a cautionary tale for foragers.
One of the most striking examples is the black fungus *Cryptococcus neoformans*, which has been found growing on the walls of the damaged reactor itself. This fungus appears to use melanin, a pigment that also protects human skin from UV radiation, to convert gamma radiation into chemical energy through a process known as radiosynthesis. While this doesn’t mean mushrooms are “feeding” on radiation in the traditional sense, it does suggest they can harness it to gain a competitive edge in an environment where few other organisms can survive. For researchers, this raises questions about the potential for radiation-resistant fungi in bioremediation efforts, though practical applications remain speculative.
Foraging for mushrooms in the Chernobyl area is not just risky—it’s illegal. Despite this, wild mushrooms from contaminated regions occasionally make their way into local markets, posing a health risk due to their high radionuclide content. A 2019 study found that *Boletus* species, commonly known as porcini, can accumulate cesium-137 at levels up to 300 Bq/kg, far exceeding the European Union’s safety limit of 600 Bq/kg for food. To stay safe, avoid consuming wild mushrooms from areas with known radiation exposure, and always use a Geiger counter if foraging near former nuclear sites. Even seemingly pristine forests can harbor hidden dangers decades after contamination.
Comparing Chernobyl’s fungal ecosystem to other radioactive environments, such as the Hanford Site in Washington State, reveals both similarities and differences. While mushrooms in both locations exhibit radiation tolerance, the species composition varies based on climate and soil conditions. Chernobyl’s temperate forests favor wood-decaying fungi like *Cortinarius* and *Mycena*, whereas Hanford’s arid landscape supports more heat-resistant varieties. This diversity underscores the adaptability of fungi across extreme environments, though it also complicates efforts to generalize their behavior in radiation-affected areas.
In conclusion, mushrooms in the Chernobyl ecosystem offer a window into the complex interplay between life and radiation. Their ability to thrive in such conditions challenges our understanding of biological limits and highlights the importance of caution when interacting with contaminated environments. Whether as a scientific curiosity, a potential tool for bioremediation, or a warning for foragers, Chernobyl’s fungi remind us that even in the aftermath of disaster, life finds a way—though not always in forms safe for human consumption.
Can Mushrooms Thrive in Poop? Exploring Unusual Growth Environments
You may want to see also
Explore related products

Radiation absorption by mycelium
Mycelium, the vegetative part of fungi, has demonstrated a remarkable ability to absorb and accumulate certain heavy metals and radioactive isotopes from its environment. This process, known as bioremediation, leverages the mycelium’s extensive network to bind and concentrate contaminants, effectively reducing their mobility in soil and water. For instance, studies have shown that *Pleurotus ostreatus* (oyster mushroom) mycelium can absorb cesium-137 and strontium-90, radioactive isotopes commonly found in nuclear waste. The mycelium’s cell walls, rich in chitin and glucans, act as natural chelators, trapping these elements and preventing their spread. This capability has led to experiments in Chernobyl’s Exclusion Zone, where mycelium has been used to mitigate radiation in contaminated soil.
To harness mycelium’s radiation-absorbing potential, follow these steps: first, inoculate contaminated soil with mycelium spores or mycelium-infused substrate. Ensure the environment is humid and nutrient-rich to support growth. Monitor the area regularly, as mycelium can spread rapidly under optimal conditions. After several weeks, harvest the mycelium and dispose of it safely, as it will have accumulated radioactive particles. Caution: avoid consuming mushrooms grown in contaminated areas, as they may concentrate harmful isotopes. For large-scale projects, consult experts in mycoremediation to design effective strategies tailored to specific radiation levels, which can range from low-dose (1–10 mSv/year) to high-dose (50+ mSv/year) environments.
While mycelium’s ability to absorb radiation is promising, it is not a cure-all. The process is most effective for surface-level contamination and may not address deep-seated radioactive materials. Additionally, the mycelium itself becomes radioactive after absorption, requiring careful handling and disposal. Comparative studies show that mycelium outperforms traditional chemical methods in certain scenarios, particularly in organic-rich soils. However, its efficiency decreases in highly acidic or alkaline environments, where mycelium growth is inhibited. Practical applications include post-nuclear disaster cleanup and remediation of industrial sites with low-level radioactive waste, typically involving doses under 100 mSv/year.
Descriptively, the mycelium’s role in radiation absorption resembles a natural filtration system. Imagine a sprawling network of thread-like structures, each strand acting as a microscopic magnet for radioactive particles. As the mycelium grows, it forms a living barrier that traps cesium, strontium, and other contaminants, effectively “cleaning” the soil. This process is particularly vivid in areas like Fukushima, where mycelium has been observed colonizing radioactive wood and debris. Over time, the once-contaminated soil transforms into a more stable, less hazardous environment, showcasing the resilience and utility of fungi in extreme conditions.
Persuasively, investing in mycelium-based bioremediation offers a sustainable, cost-effective solution to radiation contamination. Unlike mechanical or chemical methods, mycelium requires minimal energy input and leaves no harmful residues. Its ability to thrive in diverse ecosystems—from forests to urban areas—makes it a versatile tool for global radiation cleanup efforts. Governments and organizations should prioritize research and funding for mycoremediation projects, especially in regions affected by nuclear accidents or industrial pollution. By leveraging nature’s own mechanisms, we can address one of the most persistent environmental challenges of our time.
Mushrooms in Coal Mines: Unlikely Fungi Growth in Dark Depths
You may want to see also

Mushrooms in nuclear cleanup efforts
Mushrooms, particularly certain species like *Oyster* and *Reishi*, exhibit a remarkable ability to thrive in environments with elevated radiation levels, a phenomenon known as radiotropism. This unique trait has sparked interest in their potential role in nuclear cleanup efforts, specifically through a process called mycoremediation. Unlike traditional methods that often involve costly and invasive procedures, mycoremediation leverages the natural absorptive properties of fungi to break down or accumulate radioactive isotopes, such as cesium-137 and strontium-90, which are common contaminants in nuclear disaster sites.
To implement mycoremediation effectively, start by selecting mushroom species with proven radiocesium tolerance, such as *Pleurotus ostreatus* (Oyster mushroom). These fungi can accumulate cesium-137 at concentrations up to 10,000 times higher than their surrounding soil. The process involves inoculating contaminated soil with mushroom mycelium, allowing it to grow and absorb radioactive particles over several weeks. Once the mushrooms mature, they are harvested and safely disposed of, effectively reducing soil contamination. This method has been piloted in areas like Chernobyl, where *Pleurotus* species reduced cesium levels in soil by up to 50% within 30 days.
However, mycoremediation is not without challenges. While mushrooms can accumulate radioactive isotopes, they do not degrade them, meaning harvested biomass remains hazardous. Proper disposal, such as incineration in specialized facilities, is critical to prevent further contamination. Additionally, the process is most effective in specific conditions—moisture levels between 50-70%, temperatures of 15-25°C, and pH levels of 6-8. Deviations from these parameters can hinder fungal growth and reduce remediation efficiency.
A comparative analysis highlights the advantages of mycoremediation over conventional methods like chemical washing or excavation. Traditional techniques often disrupt ecosystems, require extensive machinery, and generate secondary waste. In contrast, mycoremediation is low-cost, minimally invasive, and supports soil health by improving structure and nutrient cycling. For instance, in a 2018 study, mycoremediation reduced cleanup costs by 30% compared to chemical treatments in a simulated nuclear spill site.
In conclusion, mushrooms offer a promising, nature-based solution for nuclear cleanup, particularly in areas where conventional methods are impractical or too expensive. By understanding their capabilities and limitations, stakeholders can harness this innovative approach to restore contaminated environments. Practical tips include monitoring mycelium growth weekly, ensuring proper aeration, and collaborating with local mycologists to optimize species selection for specific contaminants. As research advances, mycoremediation could become a cornerstone of sustainable nuclear waste management.
Mushrooms in Dog Poop: Unlikely Growth or Common Occurrence?
You may want to see also
Frequently asked questions
Yes, certain mushroom species, known as radiotrophic fungi, can grow in radioactive environments. They have been observed thriving in areas with high radiation levels, such as the Chernobyl Exclusion Zone.
Some mushrooms, like *Cladosporium sphaerospermum*, produce melanin, which helps them absorb and convert radiation into chemical energy, aiding their survival in radioactive conditions.
No, mushrooms growing in radioactive environments can accumulate harmful radionuclides, making them unsafe for consumption. Eating such mushrooms poses serious health risks, including radiation poisoning.
No, only specific species of fungi, like radiotrophic fungi, have adapted to survive in radioactive environments. Most mushrooms cannot tolerate high radiation levels and would not grow in such conditions.











































